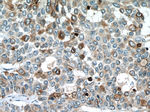
RAB27A Antibody in Immunohistochemistry (Paraffin) (IHC (P))

Search
Proteintech
RAB27A Monoclonal Antibody (1C4B8)
{{$productOrderCtrl.translations['antibody.pdp.commerceCard.promotion.promotions']}}
{{$productOrderCtrl.translations['antibody.pdp.commerceCard.promotion.viewpromo']}}
{{$productOrderCtrl.translations['antibody.pdp.commerceCard.promotion.promocode']}}: {{promo.promoCode}} {{promo.promoTitle}} {{promo.promoDescription}}. {{$productOrderCtrl.translations['antibody.pdp.commerceCard.promotion.learnmore']}}
产品信息
66058-1-IG
种属反应
宿主/亚型
分类
类型
克隆号
抗原
偶联物
形式
浓度
规格
纯化类型
保存液
内含物
保存条件
运输条件
产品详细信息
Immunogen sequence: MSDGDYDYL IKFLALGDSG VGKTSVLYQY TDGKFNSKFI TTVGIDFREK RVVYRASGPD GATGRGQRIH LQLWDTAGQE RFRSLTTAFF RDAMGFLLLF DLTNEQSFLN VRNWISQLQM HAYCENPDIV LCGNKSDLED QRVVKEEEAI ALAEKYGIPY FETSAANGTN ISQAIEMLLD LIMKRMERCV DKSWIPEGVV RSNGHASTDQ LSEEKEKGAC GC (1-221 aa encoded by BC107680)
靶标信息
The protein encoded by this gene belongs to the small GTPase superfamily, Rab family. The protein is membrane-bound and may be involved in protein transport and small GTPase mediated signal transduction. Mutations in this gene are associated with Griscelli syndrome type 2. Alternative splicing occurs at this locus and four transcript variants encoding the same protein have been identified. Plays a role in cytotoxic granule exocytosis in lymphocytes. Required for both granule maturation and granule docking and priming at the immunologic synapse.
仅用于科研。不用于诊断过程。未经明确授权不得转售。
篇参考文献 (0)
生物信息学
蛋白别名: ashen; GTP-binding protein Ram; mutant Ras-related protein Rab-27A; Rab-27; RAB27A; Ras-related protein Rab-27A; unnamed protein product
基因别名: 2210402C08Rik; 2410003M20Rik; 4933437C11Rik; ash; GS2; HsT18676; RAB27; RAB27A; RAM
UniProt ID: (Human) P51159, (Mouse) Q9ERI2
Entrez Gene ID: (Human) 5873, (Mouse) 11891